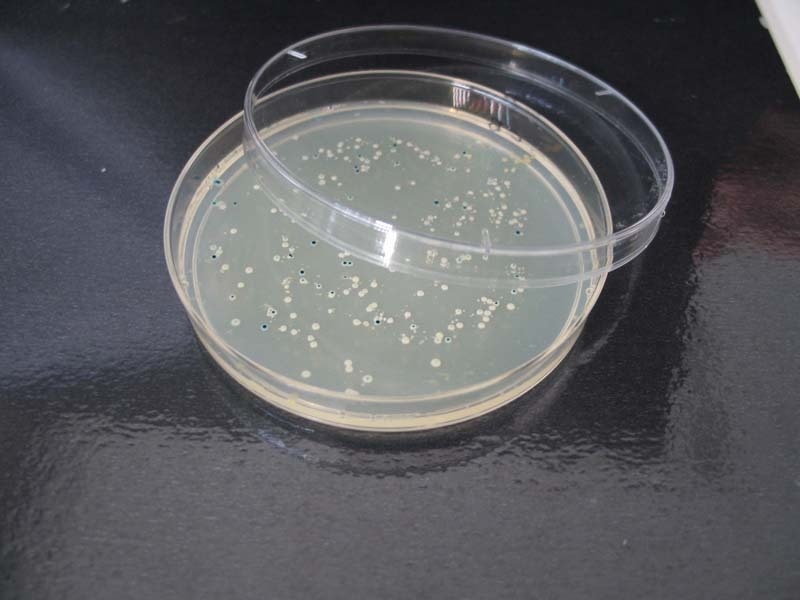
Placa Petri con colonias de bacterias creciendo. Fuente: UGR.

Un equipo de investigadores de The Australian National University (ANU) ha encontrado una relación insólita entre la resistencia a los antibióticos -un grave problema de salud pública- y el mal gobierno y la corrupción en todo el mundo.
El investigador principal del trabajo, Peter Collignon, explica en un comunicado de la ANU difundido por Eurekalert!, que el aumento de las infecciones resistentes a los antibióticos es una de las mayores amenazas que enfrenta la medicina moderna.
De hecho, solo en Estados Unidos, alrededor de 23 mil muertes y dos millones de enfermedades cada año se han atribuido a bacterias resistentes a los antibióticos.
Un hallazgo sorprendente
Pero el problema se extiende por todas partes. La Organización Mundial de la Salud lo ha descrito como una crisis venidera en la que infecciones comunes y tratables pasarán a poner en peligro la vida.
Las causas son diversas, algunas de ellas aparentemente alejadas del problema en sí. Porque, además de la más obvia -el hecho de que el uso excesivo de estos medicamentos haga que las bacterias desarrollen resistencia a ellos-, existen otras causas que también juegan un papel, como las depuradoras de aguas residuales o el estrés bacteriano.
Ahora se añade a esta lista otra causa "extraña" más: "Encontramos que el mal gobierno y niveles más altos de corrupción están asociados con mayores niveles de resistencia a los antibióticos", explica Collgnon. "Es un hallazgo que será sorprendente para la mayoría de los profesionales del campo de la medicina."
El profesor Collignon añade que, por tanto, la presente investigación sugiere que la lucha contra la corrupción y el control de antibióticos (buena gestión gubernamental del tema) podría ayudar a que haya una resistencia antibiótica inferior y, en consecuencia, a salvar vidas.
El investigador principal del trabajo, Peter Collignon, explica en un comunicado de la ANU difundido por Eurekalert!, que el aumento de las infecciones resistentes a los antibióticos es una de las mayores amenazas que enfrenta la medicina moderna.
De hecho, solo en Estados Unidos, alrededor de 23 mil muertes y dos millones de enfermedades cada año se han atribuido a bacterias resistentes a los antibióticos.
Un hallazgo sorprendente
Pero el problema se extiende por todas partes. La Organización Mundial de la Salud lo ha descrito como una crisis venidera en la que infecciones comunes y tratables pasarán a poner en peligro la vida.
Las causas son diversas, algunas de ellas aparentemente alejadas del problema en sí. Porque, además de la más obvia -el hecho de que el uso excesivo de estos medicamentos haga que las bacterias desarrollen resistencia a ellos-, existen otras causas que también juegan un papel, como las depuradoras de aguas residuales o el estrés bacteriano.
Ahora se añade a esta lista otra causa "extraña" más: "Encontramos que el mal gobierno y niveles más altos de corrupción están asociados con mayores niveles de resistencia a los antibióticos", explica Collgnon. "Es un hallazgo que será sorprendente para la mayoría de los profesionales del campo de la medicina."
El profesor Collignon añade que, por tanto, la presente investigación sugiere que la lucha contra la corrupción y el control de antibióticos (buena gestión gubernamental del tema) podría ayudar a que haya una resistencia antibiótica inferior y, en consecuencia, a salvar vidas.
La pobreza no afecta; la corrupción, sí
La investigación examinó la resistencia a los antibióticos en Europa, tanto desde el punto de vista médico como desde el punto de vista político-económico.
Descubrió lo siguiente: Por una parte, que el nivel de resistencia a los antibióticos de un país no está relacionado con su riqueza. Por tanto, "los países más pobres no deben considerar la resistencia a los antibióticos como una consecuencia inevitable de su situación financiera", afirman los autores de la investigación.
Por otra parte, también que los países con mayores niveles de corrupción a menudo tienen procesos menos rigurosos y menos transparentes, y controles menos eficaces en áreas pertinentes a la resistencia a los antibióticos.
"Estos (procesos) incluyen factores que afectan al uso de los antibióticos y a la manera en que bacterias resistentes a los antibióticos se propagan a través del agua y los alimentos; así como un control de infecciones deficiente", explica Sanjaya Senanayake, coautor del estudio. Además, añade, "en los países con más corrupción, el uso de antibióticos también puede ser mucho mayor que lo que se registra".
Mayores niveles de resistencia en el sector privado
Otro hallazgo del estudio fue que hay mayores niveles de resistencia a los antibióticos en el sector privado de la asistencia sanitaria. "Esto puede ser porque los médicos, en el sistema privado de salud, están sujetos a menos controles sobre el uso de antibióticos, tanto en volumen como en tipos", afirma Senanayake.
"Si los problemas de gobernabilidad y corrupción pueden ser mejor atendidos, es muy probable que haya grandes reducciones en los niveles de resistencia a los antibióticos; lo que a su vez dará lugar a muchos otros beneficios a nivel mundial", concluyen los científicos.
La investigación examinó la resistencia a los antibióticos en Europa, tanto desde el punto de vista médico como desde el punto de vista político-económico.
Descubrió lo siguiente: Por una parte, que el nivel de resistencia a los antibióticos de un país no está relacionado con su riqueza. Por tanto, "los países más pobres no deben considerar la resistencia a los antibióticos como una consecuencia inevitable de su situación financiera", afirman los autores de la investigación.
Por otra parte, también que los países con mayores niveles de corrupción a menudo tienen procesos menos rigurosos y menos transparentes, y controles menos eficaces en áreas pertinentes a la resistencia a los antibióticos.
"Estos (procesos) incluyen factores que afectan al uso de los antibióticos y a la manera en que bacterias resistentes a los antibióticos se propagan a través del agua y los alimentos; así como un control de infecciones deficiente", explica Sanjaya Senanayake, coautor del estudio. Además, añade, "en los países con más corrupción, el uso de antibióticos también puede ser mucho mayor que lo que se registra".
Mayores niveles de resistencia en el sector privado
Otro hallazgo del estudio fue que hay mayores niveles de resistencia a los antibióticos en el sector privado de la asistencia sanitaria. "Esto puede ser porque los médicos, en el sistema privado de salud, están sujetos a menos controles sobre el uso de antibióticos, tanto en volumen como en tipos", afirma Senanayake.
"Si los problemas de gobernabilidad y corrupción pueden ser mejor atendidos, es muy probable que haya grandes reducciones en los niveles de resistencia a los antibióticos; lo que a su vez dará lugar a muchos otros beneficios a nivel mundial", concluyen los científicos.
Referencia bibliográfica:
Peter Collignon, Prema-Chandra Athukorala, Sanjaya Senanayake, Fahad Khan. Antimicrobial Resistance: The Major Contribution of Poor Governance and Corruption to This Growing Problem. PLOS ONE (2015). DOI: 10.1371/journal.pone.0116746.
Peter Collignon, Prema-Chandra Athukorala, Sanjaya Senanayake, Fahad Khan. Antimicrobial Resistance: The Major Contribution of Poor Governance and Corruption to This Growing Problem. PLOS ONE (2015). DOI: 10.1371/journal.pone.0116746.

 Tendencias Científicas
Tendencias Científicas

El corazón débil también daña al cerebro
El corazón débil también daña al cerebro CIENCIA ON LINE
CIENCIA ON LINE